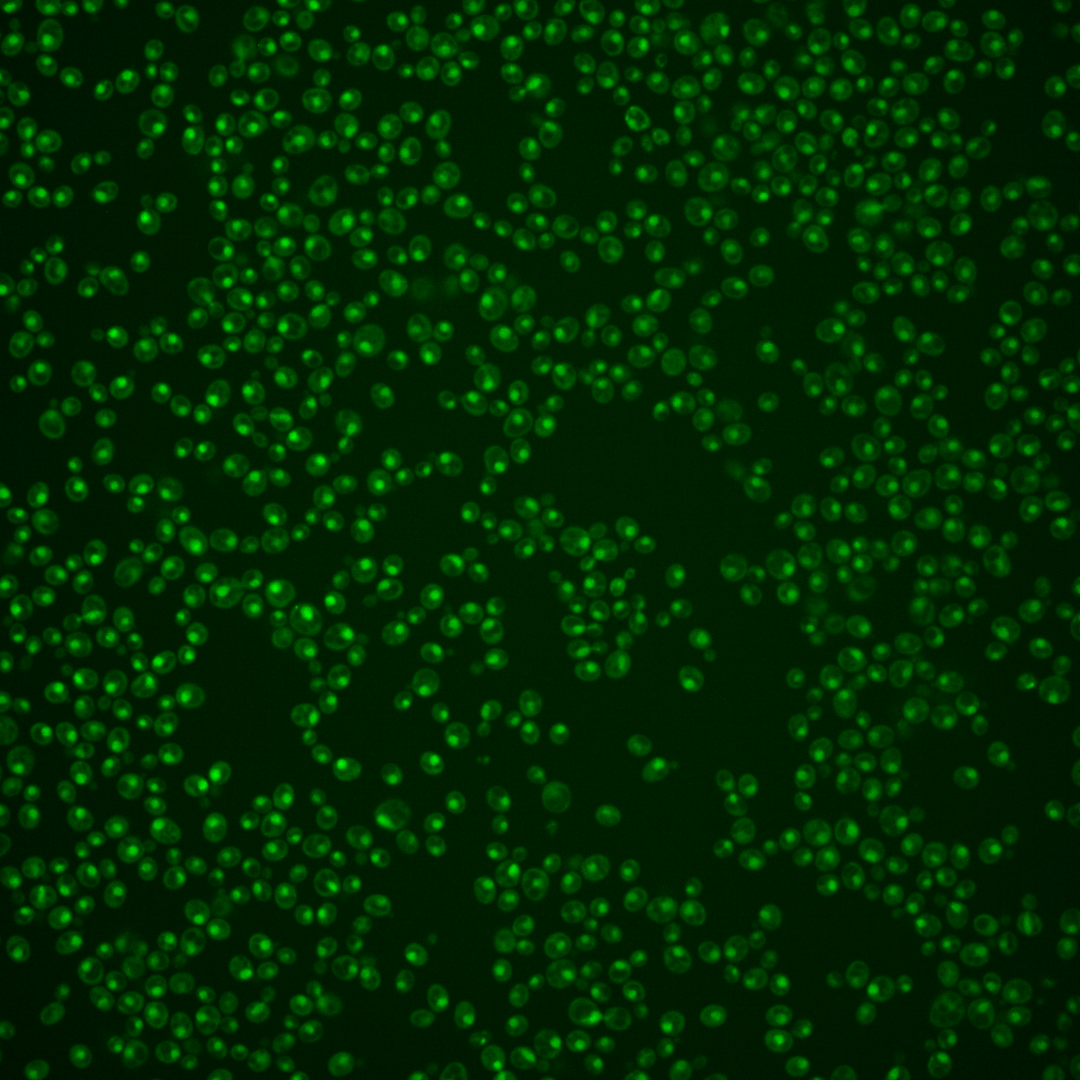

| Standard name | |
|---|---|
| Human Ortholog | |
| Description | Subunit of the Hap2p/3p/4p/5p CCAAT-binding complex; complex is heme-activated and glucose-repressed; complex is a transcriptional activator and global regulator of respiratory gene expression; contains sequences sufficient for both complex assembly and DNA binding; respiratory defect of the null mutant is functionally complemented by human NFYA |
Micrographs




















































































Sub-cellular Localization
Yeast GFP Assignment
Protein Abundance
Localization Change
External localization resources
| ensLOC | DeepLoc | |||||||||||||||||||||||
|---|---|---|---|---|---|---|---|---|---|---|---|---|---|---|---|---|---|---|---|---|---|---|---|---|
| Localization | WT1 | WT2 | WT3 | RAP60 | RAP140 | RAP220 | RAP300 | RAP380 | RAP460 | RAP540 | RAP620 | RAP700 | HU80 | HU120 | HU160 | rpd3Δ_1 | rpd3Δ_2 | rpd3Δ_3 | WT1 | WT2 | WT3 | AF100 | AF140 | AF180 |
| Cortical Patches | 0 | 0 | 0 | – | 0 | 0 | 0 | – | 0 | 0 | 0 | 0 | 0 | 0 | 0 | – | – | – | 0 | 1 | 0 | 0 | 0 | 1 |
| Bud | 0 | 0 | 0 | – | 1 | 0 | 0 | – | 0 | 1 | 1 | 0 | 0 | 0 | 0 | – | – | – | 2 | 0 | 1 | 2 | 0 | 3 |
| Bud Neck | 0 | 1 | 0 | – | 0 | 0 | 0 | – | 0 | 0 | 0 | 0 | 0 | 0 | 0 | – | – | – | 0 | 0 | 0 | 0 | 0 | 1 |
| Bud Site | 0 | 1 | 0 | – | 0 | 2 | 1 | – | 5 | 2 | 8 | 5 | 0 | 0 | 0 | – | – | – | – | – | – | – | – | – |
| Cell Periphery | 0 | 0 | 0 | – | 0 | 0 | 0 | – | 0 | 0 | 0 | 0 | 1 | 0 | 0 | – | – | – | 0 | 0 | 0 | 0 | 0 | 0 |
| Cytoplasm | 1 | 4 | 4 | – | 1 | 1 | 11 | – | 5 | 5 | 1 | 3 | 42 | 64 | 88 | – | – | – | 1 | 4 | 0 | 1 | 5 | 5 |
| Endoplasmic Reticulum | 0 | 1 | 0 | – | 0 | 0 | 0 | – | 0 | 0 | 0 | 0 | 0 | 1 | 1 | – | – | – | 0 | 0 | 0 | 0 | 0 | 1 |
| Endosome | 0 | 1 | 0 | – | 0 | 1 | 0 | – | 0 | 0 | 0 | 0 | 0 | 2 | 4 | – | – | – | 1 | 1 | 0 | 0 | 3 | 6 |
| Golgi | 0 | 0 | 0 | – | 0 | 0 | 0 | – | 0 | 0 | 0 | 0 | 1 | 0 | 1 | – | – | – | 0 | 0 | 0 | 0 | 1 | 0 |
| Mitochondria | 20 | 47 | 1 | – | 0 | 2 | 18 | – | 29 | 34 | 30 | 25 | 2 | 0 | 1 | – | – | – | 2 | 3 | 0 | 2 | 1 | 7 |
| Nucleus | 97 | 144 | 72 | – | 83 | 122 | 157 | – | 94 | 92 | 81 | 84 | 309 | 341 | 336 | – | – | – | 105 | 148 | 72 | 185 | 279 | 267 |
| Nuclear Periphery | 0 | 3 | 0 | – | 0 | 1 | 3 | – | 2 | 1 | 0 | 2 | 0 | 0 | 0 | – | – | – | 0 | 0 | 0 | 0 | 1 | 1 |
| Nucleolus | 2 | 3 | 0 | – | 1 | 3 | 5 | – | 11 | 14 | 27 | 25 | 0 | 0 | 4 | – | – | – | 0 | 0 | 1 | 4 | 9 | 20 |
| Peroxisomes | 0 | 0 | 0 | – | 0 | 0 | 0 | – | 0 | 0 | 0 | 0 | 0 | 2 | 2 | – | – | – | 0 | 0 | 0 | 0 | 0 | 0 |
| SpindlePole | 0 | 0 | 1 | – | 0 | 1 | 2 | – | 0 | 0 | 1 | 0 | 1 | 3 | 4 | – | – | – | 0 | 0 | 1 | 1 | 3 | 5 |
| Vac/Vac Membrane | 0 | 3 | 1 | – | 0 | 1 | 2 | – | 0 | 0 | 1 | 0 | 1 | 3 | 7 | – | – | – | 4 | 13 | 3 | 11 | 31 | 55 |
| Unique Cell Count | 105 | 166 | 77 | 85 | 128 | 177 | 108 | 117 | 104 | 107 | 353 | 410 | 436 | 120 | 176 | 86 | 212 | 342 | 387 | |||||
| Labelled Cell Count | 120 | 208 | 79 | 86 | 134 | 199 | 146 | 149 | 150 | 144 | 357 | 416 | 448 | 120 | 176 | 86 | 212 | 342 | 387 | |||||
Yeast GFP Assignment
Protein Abundance
| Screen | WT1 | WT2 | WT3 | RAP60 | RAP140 | RAP220 | RAP300 | RAP380 | RAP460 | RAP540 | RAP620 | RAP700 | HU80 | HU120 | HU160 | rpd3Δ_1 | rpd3Δ_2 | rpd3Δ_3 | AF100 | AF140 | AF180 |
|---|---|---|---|---|---|---|---|---|---|---|---|---|---|---|---|---|---|---|---|---|---|
| Mean Cell GFP Intensity (1e-4) | 4.7 | 5.1 | 6.0 | – | 6.3 | 5.9 | 5.5 | – | 5.3 | 4.9 | 5.1 | 5.3 | 6.5 | 6.9 | 6.9 | – | – | – | 6.9 | 7.2 | 7.4 |
| Std Deviation (1e-4) | 0.7 | 5.4 | 1.1 | – | 0.8 | 1.1 | 1.4 | – | 1.2 | 1.0 | 1.4 | 1.5 | 1.3 | 1.5 | 2.2 | – | – | – | 1.4 | 1.7 | 1.8 |
| Intensity Change (Log2) | – | – | – | – | 0.08 | -0.03 | -0.13 | – | -0.17 | -0.3 | -0.24 | -0.19 | 0.12 | 0.2 | 0.2 | – | – | – | 0.21 | 0.26 | 0.31 |
Localization Change
| Localization | RAP60 | RAP140 | RAP220 | RAP300 | RAP380 | RAP460 | RAP540 | RAP620 | RAP700 | HU80 | HU120 | HU160 | rpd3Δ_1 | rpd3Δ_2 | rpd3Δ_3 |
|---|---|---|---|---|---|---|---|---|---|---|---|---|---|---|---|
| Cortical Patches | – | 0 | 0 | 0 | – | 0 | 0 | 0 | 0 | 0 | 0 | 0 | – | – | – |
| Bud | – | 0 | 0 | 0 | – | 0 | 0 | 0 | 0 | 0 | 0 | 0 | – | – | – |
| Bud Neck | – | 0 | 0 | 0 | – | 0 | 0 | 0 | 0 | 0 | 0 | 0 | – | – | – |
| Bud Site | – | 0 | 0 | 0 | – | 0 | 0 | 0 | 0 | 0 | 0 | 0 | – | – | – |
| Cell Periphery | – | 0 | 0 | 0 | – | 0 | 0 | 0 | 0 | 0 | 0 | 0 | – | – | – |
| Cytoplasm | – | 0 | 0 | 0 | – | 0 | 0 | 0 | 0 | 1.7 | 2.4 | 3.2 | – | – | – |
| Endoplasmic Reticulum | – | 0 | 0 | 0 | – | 0 | 0 | 0 | 0 | 0 | 0 | 0 | – | – | – |
| Endosome | – | 0 | 0 | 0 | – | 0 | 0 | 0 | 0 | 0 | 0 | 0 | – | – | – |
| Golgi | – | 0 | 0 | 0 | – | 0 | 0 | 0 | 0 | 0 | 0 | 0 | – | – | – |
| Mitochondria | – | 0 | 0 | 2.5 | – | 4.6 | 0 | 4.9 | 4.2 | 0 | 0 | 0 | – | – | – |
| Nucleus | – | 1.3 | 0.6 | -1.2 | – | -1.4 | -2.8 | -2.9 | -2.8 | -1.5 | -2.3 | -3.3 | – | – | – |
| Nuclear Periphery | – | 0 | 0 | 0 | – | 0 | 0 | 0 | 0 | 0 | 0 | 0 | – | – | – |
| Nucleolus | – | 0 | 0 | 0 | – | 0 | 0 | 4.8 | 4.6 | 0 | 0 | 0 | – | – | – |
| Peroxisomes | – | 0 | 0 | 0 | – | 0 | 0 | 0 | 0 | 0 | 0 | 0 | – | – | – |
| SpindlePole | – | 0 | 0 | 0 | – | 0 | 0 | 0 | 0 | 0 | 0 | 0 | – | – | – |
| Vacuole | – | 0 | 0 | 0 | – | 0 | 0 | 0 | 0 | 0 | 0 | 0 | – | – | – |
External localization resources
Images






























Protein Concentration and Protein Localization Data
| R1 | R2 | R3 | ||||||||||||||||
|---|---|---|---|---|---|---|---|---|---|---|---|---|---|---|---|---|---|---|
| G1 Pre-START | G1 Post-START | S/G2 | Metaphase | Anaphase | Telophase | G1 Pre-START | G1 Post-START | S/G2 | Metaphase | Anaphase | Telophase | G1 Pre-START | G1 Post-START | S/G2 | Metaphase | Anaphase | Telophase | |
| Concentration | 1.7396 | 1.5246 | 1.3781 | 1.3975 | 1.1355 | 1.5299 | 5.7084 | 5.1886 | 5.3343 | 5.0059 | 5.1836 | 5.3762 | 3.0844 | 2.4271 | 2.6348 | 1.9115 | 2.1852 | 2.4511 |
| Actin | 0.0195 | 0 | 0.0023 | 0 | 0 | 0.0002 | 0.0068 | 0 | 0.0148 | 0.0044 | 0.0035 | 0.0001 | 0.0235 | 0 | 0.0083 | 0 | 0.022 | 0.0001 |
| Bud | 0.0001 | 0 | 0 | 0 | 0 | 0 | 0.0005 | 0 | 0.0008 | 0.001 | 0.0004 | 0 | 0.0002 | 0 | 0.0002 | 0 | 0.0004 | 0.0001 |
| Bud Neck | 0.0001 | 0.0002 | 0.0001 | 0 | 0.0002 | 0.001 | 0.0031 | 0.0001 | 0.0031 | 0.0002 | 0.004 | 0.0008 | 0.0022 | 0.0001 | 0.0007 | 0.0001 | 0.0025 | 0.0011 |
| Bud Periphery | 0.0002 | 0 | 0 | 0 | 0 | 0.0001 | 0.001 | 0 | 0.0015 | 0.0033 | 0.0011 | 0.0001 | 0.0002 | 0 | 0.0003 | 0 | 0.0005 | 0.0001 |
| Bud Site | 0.0002 | 0.0001 | 0.0001 | 0 | 0 | 0.0002 | 0.0043 | 0.0001 | 0.0079 | 0.0031 | 0.0009 | 0.0001 | 0.0013 | 0.0001 | 0.0007 | 0 | 0.0058 | 0.0002 |
| Cell Periphery | 0 | 0 | 0 | 0 | 0 | 0 | 0.0004 | 0 | 0.0005 | 0.0002 | 0.0003 | 0 | 0.0001 | 0 | 0.0001 | 0 | 0.0002 | 0 |
| Cytoplasm | 0.0019 | 0.0005 | 0.0002 | 0 | 0.0002 | 0.0001 | 0.0055 | 0.0023 | 0.0033 | 0.0012 | 0.0024 | 0.0002 | 0.0189 | 0.0006 | 0.005 | 0.0001 | 0.0027 | 0.0018 |
| Cytoplasmic Foci | 0.0015 | 0.0013 | 0.0006 | 0 | 0 | 0.0009 | 0.0063 | 0 | 0.0039 | 0.0005 | 0.0067 | 0 | 0.0228 | 0 | 0.0047 | 0 | 0.0115 | 0.0001 |
| Eisosomes | 0.0001 | 0 | 0 | 0 | 0 | 0 | 0.0001 | 0 | 0.0001 | 0.0001 | 0.0001 | 0 | 0.0002 | 0 | 0.0001 | 0 | 0.0002 | 0 |
| Endoplasmic Reticulum | 0.0009 | 0 | 0 | 0 | 0 | 0.0001 | 0.0051 | 0.0001 | 0.0028 | 0.0036 | 0.0017 | 0.0001 | 0.0037 | 0.0001 | 0.0016 | 0 | 0.0015 | 0.0002 |
| Endosome | 0.0041 | 0.0003 | 0.0002 | 0 | 0 | 0.0011 | 0.0268 | 0.0002 | 0.0136 | 0.0046 | 0.0173 | 0.0004 | 0.02 | 0.0001 | 0.0112 | 0 | 0.0095 | 0.0009 |
| Golgi | 0.0015 | 0.0001 | 0.0003 | 0 | 0 | 0.0002 | 0.0103 | 0 | 0.0057 | 0.0016 | 0.0072 | 0 | 0.004 | 0 | 0.0039 | 0 | 0.0032 | 0 |
| Lipid Particles | 0.0036 | 0.0001 | 0.0022 | 0 | 0 | 0.0022 | 0.0163 | 0 | 0.0064 | 0.001 | 0.0205 | 0.0002 | 0.0067 | 0 | 0.0049 | 0 | 0.0091 | 0.0001 |
| Mitochondria | 0.0011 | 0.0001 | 0.0003 | 0 | 0.0005 | 0.0003 | 0.0203 | 0.0002 | 0.017 | 0.0166 | 0.0044 | 0.0005 | 0.0011 | 0.0001 | 0.0019 | 0.0001 | 0.0016 | 0.0002 |
| None | 0.0014 | 0.0001 | 0.0001 | 0 | 0.0001 | 0.0002 | 0.0027 | 0.0022 | 0.0006 | 0.0003 | 0.0006 | 0.0001 | 0.0149 | 0.0001 | 0.0086 | 0 | 0.0017 | 0.0013 |
| Nuclear Periphery | 0.0064 | 0.0011 | 0.0017 | 0.0003 | 0.0021 | 0.0012 | 0.0479 | 0.0034 | 0.0058 | 0.0024 | 0.0372 | 0.0033 | 0.0112 | 0.0045 | 0.0039 | 0.0006 | 0.0168 | 0.0026 |
| Nucleolus | 0.0065 | 0.0118 | 0.006 | 0.0081 | 0.0373 | 0.0248 | 0.0207 | 0.0081 | 0.0062 | 0.0034 | 0.0158 | 0.0188 | 0.009 | 0.0101 | 0.0081 | 0.0049 | 0.0181 | 0.017 |
| Nucleus | 0.9462 | 0.9787 | 0.9815 | 0.9908 | 0.9584 | 0.9624 | 0.7988 | 0.9794 | 0.8864 | 0.9499 | 0.8426 | 0.9734 | 0.828 | 0.9826 | 0.9225 | 0.9938 | 0.8696 | 0.9688 |
| Peroxisomes | 0.0013 | 0.0001 | 0.003 | 0 | 0 | 0.0005 | 0.0053 | 0 | 0.0038 | 0.0007 | 0.0014 | 0 | 0.011 | 0 | 0.0031 | 0 | 0.0052 | 0 |
| Punctate Nuclear | 0.0016 | 0.0053 | 0.0015 | 0.0007 | 0.0009 | 0.0043 | 0.0092 | 0.0024 | 0.0108 | 0.0005 | 0.0257 | 0.0015 | 0.0196 | 0.0014 | 0.0082 | 0.0003 | 0.0159 | 0.0047 |
| Vacuole | 0.0009 | 0.0001 | 0 | 0 | 0.0001 | 0.0002 | 0.0058 | 0.0011 | 0.0034 | 0.0012 | 0.0036 | 0.0002 | 0.0009 | 0.0001 | 0.0014 | 0 | 0.0015 | 0.0007 |
| Vacuole Periphery | 0.0007 | 0 | 0 | 0 | 0.0001 | 0.0001 | 0.0025 | 0.0004 | 0.0014 | 0.0005 | 0.0029 | 0.0002 | 0.0004 | 0.0001 | 0.0005 | 0 | 0.0005 | 0.0001 |
Sequencing Data
| R1 | R2 | |||||||||
|---|---|---|---|---|---|---|---|---|---|---|
| G1 Post-START | S/G2 | Metaphase | Anaphase | Telophase | G1 Post-START | S/G2 | Metaphase | Anaphase | Telophase | |
| Gene Expression | 8.2963 | 9.8885 | 12.8409 | 9.5032 | 8.0674 | 9.6736 | 13.4351 | 10.544 | 10.7876 | 11.1738 |
| Translational Efficiency | 1.9042 | 2.2117 | 1.2086 | 1.5896 | 2.1842 | 2.0509 | 1.2526 | 2.0353 | 1.7213 | 1.5821 |
Hit Data
| Dataset | Hit |
|---|---|
| Protein Concentration | ✘ |
| Protein Localization | ✘ |
| Gene Expression | ✘ |
| Translational Efficiency | ✘ |
Endocytosis
| Temp | Actin Patch (Sac6-tdTomato) | Cortical Patch (Sla1-GFP) | Late Endosome (Snf7-GFP) | Vacuole (Vph1-GFP) |
|---|---|---|---|---|
| 37℃ | ||||
| RT |
Cell Cycle Omics
CYCLoPs (Hap2-GFP)
| Gene / Allele | Actin Patch (Sac6-tdTomato) | Cortical Patch (Sla1-GFP) | Late Endosome (Snf7-GFP) | Vacuole (Sac6-tdTomato) |
|---|
| Gene | Images |
|---|
| Gene | Images |
|---|
Images are not yet available
Images are not yet available